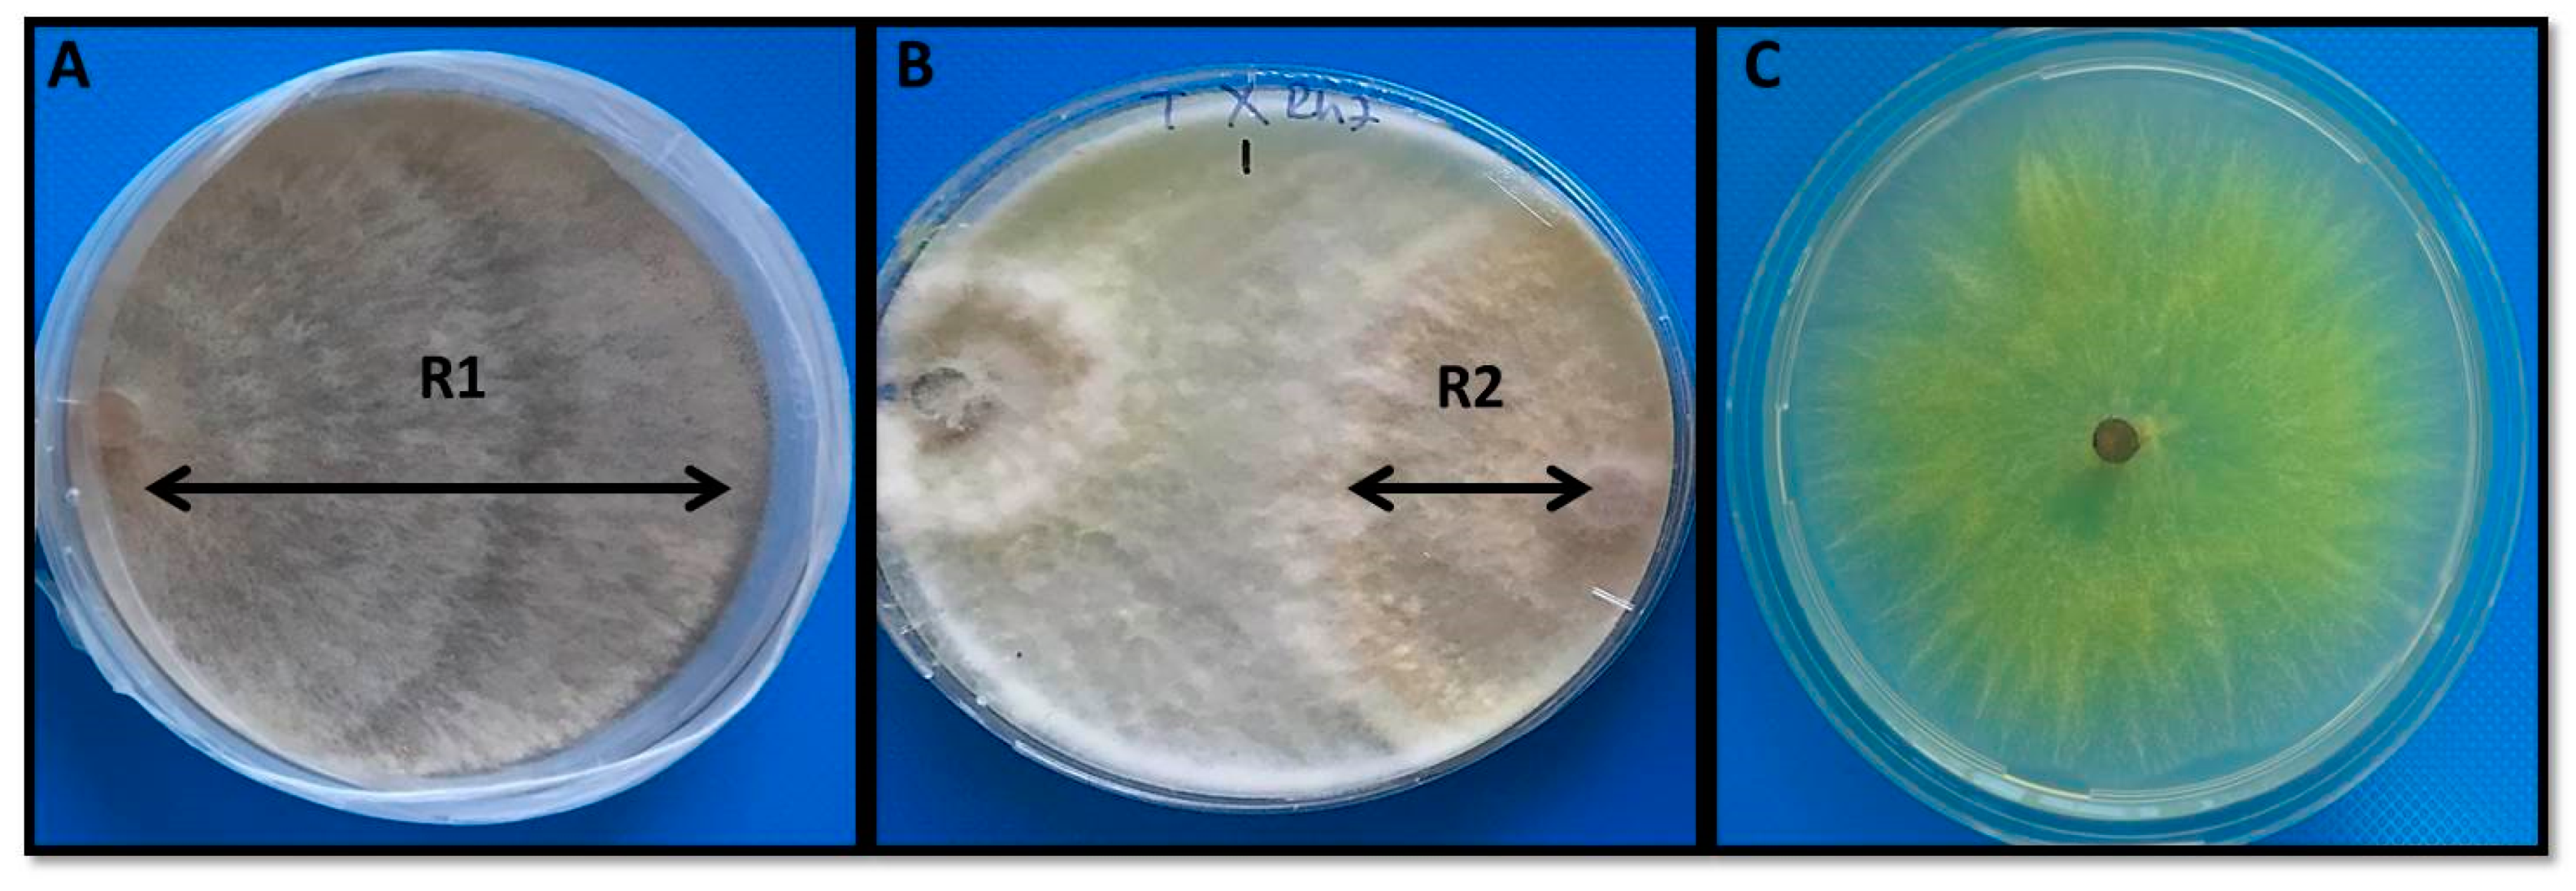
Agronomy 11 01589 g001 Agronomy 11 01589 g001

The Effect of Trichoderma citrinoviride Treatment under Salinity Combined to Rhizoctonia solani Infection in Strawberry (Fragaria x ananassa Duch.)
Abstract
1. Introduction
2. Materials and Methods
2.1. Trichoderma Citrinoviride Isolation and Identification
2.2. Rhizoctonia Solani Isolation and Identification
2.3. Bioassay Analysis
2.3.1. Bioassay of Trichoderma Isolate against R. solani
2.3.2. Bioassay of Trichoderma Isolate against Salinity
2.4. Plant Material and Treatments
2.5. Plant Growth
2.6. Fv/Fm (Maximal Efficiency of PSII Photochemistry)
2.7. Lipid Peroxidation (TBARS) Content
2.8. Determination of H2O2 Content
2.9. Enzyme Extractions and Assays
2.9.1. NADPH Oxidase (NOX) Activity
2.9.2. Superoxide Dismutase (SOD) Activity
2.9.3. Peroxidase (POX) and Cell Wall Bound POX (CWPOX) Activity
2.9.4. Statistical Analysis
3. Results
3.1. Effects of Trichoderma Citrinoviride on the Growth of R. solani
3.2. Disease Incidence
3.3. Plant Growth Analysis
3.4. Maximum Quantum Yield of PSII (Fv/Fm)
3.5. H2O2 Content
3.6. Lipid Peroxidation
3.7. NADPH Oxidase (NOX) Activity
3.8. Antioxidant Enzyme Activities
3.8.1. SOD Activity
3.8.2. POX Activity
3.8.3. CWPOX Activity
4. Discussion
5. Conclusions
Author Contributions
Funding
Institutional Review Board Statement
Informed Consent Statement
Data Availability Statement
Conflicts of Interest
References
- Foyer, C.H.; Rasool, B.; Davey, J.W.; Hancock, R.D. Cross-tolerance to biotic and abiotic stresses in plants: A focus on resistance to aphid infestation. J. Exp. Bot. 2016, 67, 2025–2037. [Google Scholar] [CrossRef]
- Chowdhury, J.; Henderson, M.; Schweizer, P.; Burton, R.A.; Fincher, G.B.; Little, A. Differential accumulation of callose, arabinoxylan and cellulose in nonpenetrated versus penetrated papillae on leaves of barley infected with Blumeria graminis f. sp. hordei. New Phytol. 2014, 204, 650–660. [Google Scholar] [CrossRef]
- Rao, G.S.; Rao Reddy, N.N.; Surekha, C. Induction of plant systemic resistance in legumes Cajanus cajan, Vigna radiata, Vigna mungo against plant pathogens Fusarium oxysporum and Alternaria alternata—A Trichoderma viride mediated reprogramming of plant defense mechanism. Int. J. Sci. Res. 2015, 6, 4270–4280. [Google Scholar]
- Nikraftar, F.; Taheri, P.; Rastegar, M.F.; Tarighi, S. Tomato partial resistance to Rhizoctonia solani involves antioxidative defense mechanisms. Physiol. Mol. Plant Pathol. 2013, 81, 74–83. [Google Scholar] [CrossRef]
- Taheri, P.; Tarighi, S. The role of pathogenesis-related proteins in the tomato-Rhizoctonia solani interaction. J. Bot. 2012, 2012, 1–6. [Google Scholar] [CrossRef]
- Asad-Uz-Zaman, M.; Bhuyian, M.R.; Khan, M.A.I.; Bhuiyan, M.K.A.; Latif, M.A. Integrated options for the management of black root rot of strawberry caused by Rhizoctonia solani Kuhn. C. R. Biol. 2015, 338, 112–120. [Google Scholar] [CrossRef] [PubMed]
- Cao, L.; Qiu, Z.; You, J.; Tan, H.; Zhou, S. Isolation and characterization of endophytic Streptomyces strains from surface-sterilized tomato (Lycopersicon esculentum) roots. Lett. Appl. Microbiol. 2004, 39, 425–430. [Google Scholar] [CrossRef]
- Ogoshi, A. Ecology and pathogenicity of anastomosis and intraspecific groups of Rhizoctonia solani Kuhn. Annu. Rev. Phytopathol. 1987, 25, 125–143. [Google Scholar] [CrossRef]
- Keijer, J.; Korsman, M.G.; Dullemans, A.M.; Houterman, P.M.; De Bree, J.; Van Silfhout, C.H. In vitro analysis of host plant specificity in Rhizoctonia solani. Plant Pathol. 1997, 46, 659–669. [Google Scholar] [CrossRef]
- Groth, D.E.; Bond, J.A. Initiation of rice sheath blight epidemics and effect of application timing of azoxystrobin on disease incidence, severity, yield, and milling quality. Plant Dis. 2006, 90, 1073–1076. [Google Scholar] [CrossRef] [PubMed]
- Youssef, S.A.; Tartoura, K.A.; Abdelraouf, G.A. Evaluation of Trichoderma harzianum and Serratia proteamaculans effect on disease suppression, stimulation of ROS-scavenging enzymes and improving tomato growth infected by Rhizoctonia solani. Biol. Control 2016, 100, 79–86. [Google Scholar] [CrossRef]
- Dangi, A.K.; Sharma, B.; Khangwal, I.; Shukla, P. Combinatorial interactions of biotic and abiotic stresses in plants and their molecular mechanisms: Systems biology approach. Mol. Biotechnol. 2018, 60, 636–650. [Google Scholar] [CrossRef]
- Nath, M.; Bhatt, D.; Prasad, R.; Tuteja, N. Reactive oxygen species (ROS) metabolism and signaling in plant-mycorrhizal association under biotic and abiotic stress conditions. In Mycorrhiza-Eco-Physiology, Secondary Metabolites, Nanomaterials; Springer: Cham, Switzerland, 2017; pp. 223–232. [Google Scholar]
- Isayenkov, S.V. Physiological and molecular aspects of salt stress in plants. Cytol. Genet. 2012, 46, 302–318. [Google Scholar] [CrossRef]
- Mehla, N.; Sindhi, V.; Josula, D.; Bisht, P.; Wani, S.H. An introduction to antioxidants and their roles in plant stress tolerance. In Reactive Oxygen Species and Antioxidant Systems in Plants: Role and Regulation under Abiotic Stress; Springer: Berlin/Heidelberg, Germany, 2017; pp. 1–23. [Google Scholar]
- Foyer, C.H.; Noctor, G. Redox homeostasis and antioxidant signaling: A metabolic interface between stress perception and physiological responses. Plant Cell 2005, 17, 1866–1875. [Google Scholar] [CrossRef] [PubMed]
- Saijo, Y.; Loo, E.P.I. Plant immunity in signal integration between biotic and abiotic stress responses. New Phytol. 2020, 225, 87–104. [Google Scholar] [CrossRef]
- Hermosa, R.; Rubio, M.B.; Cardoza, R.E.; Nicolás, C.; Monte, E.; Gutiérrez, S. The contribution of Trichoderma to balancing the costs of plant growth and defense. Int. Microbiol. 2013, 16, 69–80. [Google Scholar] [PubMed]
- Delen, N.; Özbek, T.; Yıldırım, İ. Effectivenes of tolchlofos-methyl to Rhizoctania solani isolates. J. Turk. Phytopathol. 1991, 20, 113. [Google Scholar]
- Smith, S.E.; Read, D.J. Mycorrhizal Symbiosis; Academic Press: Cambridge, MA, USA, 2010; p. 850. [Google Scholar]
- Adnan, M.; Islam, W.; Shabbir, A.; Khan, K.A.; Ghramh, H.A.; Huang, Z.; Lu, G.D. Plant defense against fungal pathogens by antagonistic fungi with Trichoderma in focus. Microb. Pathog. 2019, 129, 7–18. [Google Scholar] [CrossRef] [PubMed]
- Kobori, N.N.; Mascarin, G.M.; Jackson, M.A.; Schisler, D.A. Liquid culture production of microsclerotia and submerged conidia by Trichoderma harzianum active against damping-off disease caused by Rhizoctonia solani. Fungal Biol. 2015, 119, 179–190. [Google Scholar] [CrossRef]
- Tian, S.; Li, B.; Qin, G.; Xu, X. Plant host response to biocontrol agents. Acta Hortic. 2011, 905, 73–82. [Google Scholar] [CrossRef]
- Chowdappa, P.; Kumar, S.M.; Lakshmi, M.J.; Upreti, K.K. Growth stimulation and induction of systemic resistance in tomato against early and late blight by Bacillus subtilis OTPB1 or Trichoderma harzianum OTPB3. Biol. Control 2013, 65, 109–117. [Google Scholar] [CrossRef]
- Kumar, V.; Parkhi, V.; Kenerley, C.M.; Rathore, K.S. Defense-related gene expression and enzyme activities in transgenic cotton plants expressing an endochitinase gene from Trichoderma virens in response to interaction with Rhizoctonia solani. Planta 2009, 230, 277–291. [Google Scholar] [CrossRef]
- Nawrocka, J.; Małolepsza, U.; Szymczak, K.; Szczech, M. Involvement of metabolic components, volatile compounds, PR proteins, and mechanical strengthening in multilayer protection of cucumber plants against Rhizoctonia solani activated by Trichoderma atroviride TRS25. Protoplasma 2018, 255, 359–373. [Google Scholar] [CrossRef] [PubMed]
- Yeşilyurt, A.M.; Pehlivan, N.; Durmuş, N.; Karaoğlu, S.A. Trichoderma citrinoviride: A potent biopriming agent for the alleviation of salt stress in maize. Hacet. J. Biol. Chem. 2018, 46, 101–111. [Google Scholar] [CrossRef]
- Galli, V.; da Silva Messias, R.; Perin, E.C.; Borowski, J.M.; Bamberg, A.L.; Rombaldi, C.V. Mild salt stress improves strawberry fruit quality. LWT 2016, 73, 693–699. [Google Scholar] [CrossRef]
- Awang, Y.B.; Atherton, J.G. Growth and fruiting responses of strawberry plants grown on rockwool to shading and salinity. Sci. Hortic. 1995, 62, 25–31. [Google Scholar] [CrossRef]
- Pirlak, L.; Eşitken, A. Salinity effects on growth, proline and ion accumulation in strawberry plants. Acta Agric. Scand. Sect. B-Soil Plant Sci. 2004, 54, 189–192. [Google Scholar] [CrossRef]
- Gams, W.; Bissett, J. Morphology and identification of Trichoderma. In Trichoderma and Gliocladium; Kubicek, C.P., Harman, G.E., Eds.; Taylor & Francis: London, UK, 1998; Volume 1, pp. 1–34. [Google Scholar]
- White, T.J.; Bruns, T.; Lee, S.; Taylor, J. Amplification and direct sequencing of fungal ribosomal DNA for phylogenetics. In PCR Protocols: A Guide to Methods and Applications; Innes, M.A., Gelfand, D.H., Sninsky, J.J., White, T.J., Eds.; Academic Press: San Diego, CA, USA, 1990; pp. 315–322. [Google Scholar]
- Rahman, M.A.; Begum, M.F.; Alam, M.F. Screening of Trichoderma isolates as a biological control agent against Ceratocystis paradoxa causing pineapple disease of sugarcane. Mycobiology 2009, 37, 277–285. [Google Scholar] [CrossRef] [PubMed]
- Karaoglu-Alpay, S.; Bozdeveci, A.; Pehlivan, N. Characterization of Local Trichoderma spp. as potential bio-control agents, screening of in vitro antagonistic activities and fungicide tolerance. Hacet. J. Biol. Chem. 2018, 46, 247–261. [Google Scholar] [CrossRef]
- Madhava Rao, K.V.; Sresty, T.V.S. Antioxidative parameters in the seedlings of pigeonpea (Cajanus cajan L., Millspaugh) in response to Zn and Ni stresses. Plant Sci. 2000, 157, 113–128. [Google Scholar] [CrossRef]
- Cheeseman, J.M. Hydrogen peroxide concentrations in leaves under natural condi-tions. J. Exp. Bot. 2006, 57, 2435–2444. [Google Scholar] [CrossRef]
- Bradford, M.M. A rapid and sensitive method for the quantization of microgram quantities of protein utilizing the principle of the protein–dye binding. Anal. Biochem. 1976, 72, 248–254. [Google Scholar] [CrossRef]
- Jiang, M.; Zhang, J. Involvement of plasma membrane NADPH oxidase in abscisic acid-and water stress-induced antioxidant defense in leaves of maize seedlings. Planta 2002, 215, 1022–1030. [Google Scholar] [CrossRef] [PubMed]
- Beuchamp, C.; Fridovich, I. Isoenzymes of superoxide dismutase from wheat germ. Biochim. Biophys. Acta 1973, 317, 50–64. [Google Scholar] [CrossRef]
- Herzog, V.; Fahimi, H. Determination of the activity of peroxidase. Anal. Biochem. 1973, 55, 554–562. [Google Scholar] [CrossRef]
- Nostar, O.; Ozdemir, F.; Bor, M.; Turkan, I.; Tosun, N. Combined effects of salt stress and cucurbit downy mildew (Pseudoperospora cubensis Berk. and Curt. Rostov.) infection on growth, physiological traits and antioxidant activity in cucumber (Cucumis sativus L.) seedlings. Physiol. Mol. Plant Pathol. 2013, 83, 84–92. [Google Scholar] [CrossRef]
- Krause, M.S.; Madden, L.V.; Hoitink, H.A.J. Effect of potting mix microbial carrying capacity on biological control of Rhizoctonia damping-off of radish and Rhizoctonia crown and root rot of poinsettia. Phytopathology 2001, 91, 1116–1123. [Google Scholar] [CrossRef]
- Mayo, S.; Gutiérre, S.; Malmierca, M.G.; Lorenzana, A.; Campelo, M.P.; Hermosa, R.; Casquero, P.A. Influence of Rhizoctonia solani and Trichoderma spp. in growth of bean (Phaseolus vulgaris L.) and in the induction of plant defense-related genes. Front. Plant Sci. 2015, 6, 685. [Google Scholar] [CrossRef]
- Elmer, W.H. Influence of chloride and nitrogen formon Rhizoctonia root and crown rot of table beets. Plant Dis. 1997, 81, 635–640. [Google Scholar] [CrossRef] [PubMed][Green Version]
- Elmer, W.H.; LaMondia, J.A. Studies on the suppression of Fusarium crown and root rot with NaCl. Acta Hortic. 1999, 479, 211–218. [Google Scholar] [CrossRef]
- Elmer, W.H. Influence of Inoculum Density of Fusarium oxysporum f. sp. cyclaminis and sodium chloride on cyclamen and the development of Fusarium Wilt. Plant Dis. 2002, 86, 389–393. [Google Scholar] [CrossRef]
- Sanago, S. Response of chili pepper to Phytophthora capsici in relation to soil salinity. Plant Dis. 2004, 88, 205–209. [Google Scholar] [CrossRef]
- Ghaderi, N.; Hatami, M.R.; Mozafari, A.; Siosehmardeh, A. Change in antioxidant enzymes activity and some morphophysiological characteristics of strawberry under long-term salt stress. Physiol. Mol. Biol. Plants 2018, 24, 833–843. [Google Scholar] [CrossRef] [PubMed]
- Samadi, S.; Habibi, G.; Vaziri, A. Effects of exogenous salicylic acid on antioxidative responses, phenolic metabolism and photochemical activity of strawberry under salt stress. Iran. J. Plant Physiol. 2019, 9, 2685–2694. [Google Scholar]
- Wison, C.; Liu, X.; Lesch, S.M.; Suarez, D.L. Growth response of major USA cowpea cultivars II. Effect of salinity on leaf gas exchange. Plant Sci. 2006, 170, 1095–1101. [Google Scholar] [CrossRef]
- Jaiswal, A.K.; Elad, Y.; Graber, E.R.; Frenkel, O. Rhizoctonia solani suppression and plant growth promotion in cucumber as affected by biochar pyrolysis temperature, feedstock and concentration. Soil Biol. Biochem. 2014, 69, 110–118. [Google Scholar] [CrossRef]
- Hashem, A.; Abd-Allah, E.F.; Alqarawi, A.A.; Al Huqail, A.A.; Egamberdieva, D. Alleviation of abiotic salt stress in Ochradenus baccatus (Del.) by Trichoderma hamatum (Bonord.) Bainier. J. Plant Interact. 2014, 9, 857–868. [Google Scholar] [CrossRef]
- Saidimoradia, D.; Ghaderia, N.; Javadia, T. Salinity stress mitigation by humic acid application in strawberry (Fragaria x ananassa Duch.). Sci. Hortic. 2019, 256, 108594. [Google Scholar] [CrossRef]
- Yedidia, I.; Srivastva, A.K.; Kapulnik, Y.; Chet, I. Effect of Trichoderma harzianum on microelement concentrations increased growth of cucumber plants. Plant Soil. 2001, 235, 235–242. [Google Scholar] [CrossRef]
- Rawat, L.; Singh, Y.; Shukla, N.; Kumar, J. Seed biopriming with salinity tolerantisolates of Trichoderma harzianum alleviates salt stress in rice: Growth, physiological and biochemical characteristics. J. Plant Pathol. 2012, 94, 353–365. [Google Scholar]
- Zhang, S.; Xu, B.; Gan, Y. Application of Plant-Growth-Promoting Fungi Trichoderma longibrachiatum T6 enhances tolerance of wheat to salt stress through improvement of antioxidative defense system and gene expression. Front. Plant Sci. 2016, 7, 1405. [Google Scholar] [CrossRef]
- Ahmad, P.; Hashem, A.; Abd-Allah, E.F.; Alqarawi, A.A.; John, R.; Egamberdieva, D.; Gucel, S. Role of Trichoderma harzianum in mitigating NaCl stress in Indian mustard (Brassica juncea L.) through antioxidative defense system. Front. Plant Sci. 2015, 6, 868–883. [Google Scholar] [CrossRef] [PubMed]
- Nar, H.; Saglam, A.; Terzi, R.; Varkonyı, Z.; Kadıoğlu, A. Leaf rolling and photosystem II efficiency in Ctenanthe setosa exposed to drought stress. Photosynthetica 2009, 47, 429–436. [Google Scholar] [CrossRef]
- Guler, N.S.; Pehlivan, N.; Karaoğlu, S.A.; Guzel, S.; Bozdeveci, A. Trichoderma atroviride ID20G inoculation ameliorates drought stress-induced damages by improving antioxidant defence n maize seedlings. Acta Physiol. Plant 2016, 38, 132. [Google Scholar] [CrossRef]
- Gechev, T.S.; Van Breusegem, F.; Stone, J.M.; Denev, I.; Laloi, C. Reactive oxygen species as signals that modulate plant stress responses and programmed cell death. Bioassays 2006, 28, 1091–1101. [Google Scholar] [CrossRef]
- Shukla, N.; Awasthi, R.P.; Rawat, L. Biochemical andphysiological responses of rice (Oryza sativa L.) as influenced by Trichoderma harzianum under drought stress. Plant Physiol. Biochem. 2012, 54, 78–88. [Google Scholar] [CrossRef] [PubMed]
- Zhang, F.; Wang, Y.; Liu, C.; Chen, F.; Ge, H.; Tian, F.; Yang, T.; Ma, K.; Zhang, Y. Trichoderma harzianum mitigates salt stress in cucumber via multiple responses. Ecotoxicol. Environ. Saf. 2019, 170, 436–445. [Google Scholar] [CrossRef]
- Parida, A.K.; Das, A.B. Salt tolerance and salinity effect on plants: A review. Ecotoxicol. Environ. Saf. 2005, 60, 324–349. [Google Scholar] [CrossRef]
- Torres, M.A.; Dangl, J.L. Functions of the respiratory burst oxidase in biotic interactions, abiotic stress and development. Curr. Opin. Plant Biol. 2005, 8, 397–403. [Google Scholar] [CrossRef]
- Foreman, J.; Demidchik, V.; Bothwell, J.H.F.; Mylona, P.; Miedema, H.; Torres, M.A.; Linstead, P.; Costa, S.; Brownlee, C.; Jones, J.D.G.; et al. Reactive oxygen species produced by NADPH oxidase regulate plant cell growth, Reactive oxygen species produced by NADPH oxidase regulate plant cell growth. Nature 2003, 422, 442–446. [Google Scholar] [CrossRef]
- Liu, J.; Shabala, S.; Zhang, J.; Ma, G.; Chen, D.; Shabala, L.; Zeng, F.; Chen, Z.H.; Zhou, M.; Venkataraman, G. Melatonin improves rice salinity stress tolerance by NADPH oxidase-dependent control of the plasma membrane K+ transporters and K+ homeostasis. Plant Cell Environ. 2020, 43, 2591–2605. [Google Scholar] [CrossRef]
- Pazarlar, S.; Cetinkaya, N.; Bor, M.; Ozdemir, F. Ozone triggers different defence mechanisms against powdery mildew (Blumeria graminis DC. Speer f. sp. tritici) in susceptible and resistant wheat genotypes. Funct. Plant Biol. 2017, 44, 1016–1028. [Google Scholar] [CrossRef] [PubMed]
- Chung, J.S.; Zhu, J.K.; Bressan, R.A.; Hasegawa, P.M.; Shi, H. Reactive oxygen species mediate Na+-induced SOS1 mRNA stability in Arabidopsis. Plant J. 2008, 53, 554–565. [Google Scholar] [CrossRef] [PubMed]
- Keutgen, A.J.; Pawelzik, E. Impacts of NaCl stress on plant growth and mineral nutrient assimilation in two cultivars of strawberry. Environ. Exp. Bot. 2009, 65, 170–176. [Google Scholar] [CrossRef]
- Li, Y.; Gu, Y.; Li, J.; Xu, M.; Wei, Q.; Wang, Y.; Wei, Q.; Wang, Y. Biocontrol agent Bacillus amyloliquefaciens LJ02 induces systemic resistance against cucurbits powdery mildew. Front. Microbiol. 2015, 6, 1–15. [Google Scholar] [CrossRef] [PubMed]
- Jbir, N.; Chaibi, W.; Ammar, S.; Jemmali, A.; Ayadi, A. Root growth and lignification of two wheat species differing in their sensitivity to NaCl, in response to salt stress. CR Acad. Sci. Paris 2001, 324, 863–868. [Google Scholar] [CrossRef]
- Paranidharan, V.; Palaniswami, A.; Vidhyasekaran, P.; Velazhahan, R. Induction of enzymatic scavengers of active oxygen species in rice in response to infection by Rhizoctonia solani. Acta Physiol. Plant 2003, 25, 91–96. [Google Scholar] [CrossRef]
- Li, L.; Pan, S.; Melzer, R.; Fricke, W. Apoplastic barriers, aquaporin gene expression and root and cell hydraulic conductivity in phosphate-limited sheepgrass plants. Physiol. Plant 2020, 168, 118–132. [Google Scholar] [CrossRef]
- Lin, C.C.; Kao, C.H. NaCl induced changes in ionically bound peroxidase activity in roots of rice seedlings. Plant Soil 1999, 216, 147–153. [Google Scholar] [CrossRef]
- Chen, L.M.; Lin, C.C.; Kao, C.H. Copper toxicity in rice seedlings: Changes in antioxidative enzyme activities, H2O2 level, and cell wall peroxidase activity in roots. Bot. Bull. Acad. Sin. 2000, 41, 99–103. [Google Scholar]
- Verma, K.; Shekhawat, G.S.; Sharma, A.; Mehta, S.K.; Sharma, V. Cadmium induced oxidative stress and changes in soluble and ionically bound cell wall peroxidase activities in roots of seedling and 3–4 leaf stage plants of Brassica juncea (L.) czern. Plant Cell Rep. 2008, 27, 1261–1269. [Google Scholar] [CrossRef] [PubMed]
- Liszkay, A.; Kenk, B.; Schopher, P. Evidence for the involvement of cell wall peroxidase in the generation of hydroxyl radicals mediating extension growth. Planta 2003, 217, 658–667. [Google Scholar] [CrossRef] [PubMed]

| Dependent Variables | Independent Variables | ||||
|---|---|---|---|---|---|
| T | T + S | T + R | T + S + R | ||
| C | T + S + R | S | R | S + R | |
| Dry weight | 7.807 *** | 0.677 * | 5.303 * | 10.361 ** | 10.361 ** |
| Fv/Fm | 1.193 * | 1.958 * | 5.423 * | 17.999 ** | 17.999 ** |
| H2O2 | 0.912 * | 96.136 ** | 8.432 ** | 1.518 * | 1.518 * |
| TBARS | 0.129 ns | 5.666 * | 2.153 * | 1.008 * | 1.008 * |
| NOX | 0.319 ns | 1.469 * | 1.224 * | 1.304 * | 1.304 * |
| SOD | 0.033 ns | 1.130 * | 0.927 * | 0.075 ns | 0.075 ns |
| POX | 25.056 ** | 0.547 * | 0.587 * | 2.134 ** | 2.134 ** |
| CWPOX | 2.618 * | 21.837 ** | 1.227 * | 3.515 * | 3.515 * |
Publisher’s Note: MDPI stays neutral with regard to jurisdictional claims in published maps and institutional affiliations. |
© 2021 by the authors. Licensee MDPI, Basel, Switzerland. This article is an open access article distributed under the terms and conditions of the Creative Commons Attribution (CC BY) license (https://creativecommons.org/licenses/by/4.0/).
Share and Cite
Sekmen Cetinel, A.H.; Gokce, A.; Erdik, E.; Cetinel, B.; Cetinkaya, N. The Effect of Trichoderma citrinoviride Treatment under Salinity Combined to Rhizoctonia solani Infection in Strawberry (Fragaria x ananassa Duch.). Agronomy 2021, 11, 1589. https://doi.org/10.3390/agronomy11081589
Sekmen Cetinel AH, Gokce A, Erdik E, Cetinel B, Cetinkaya N. The Effect of Trichoderma citrinoviride Treatment under Salinity Combined to Rhizoctonia solani Infection in Strawberry (Fragaria x ananassa Duch.). Agronomy. 2021; 11(8):1589. https://doi.org/10.3390/agronomy11081589
Chicago/Turabian StyleSekmen Cetinel, Askim Hediye, Azime Gokce, Erhan Erdik, Barbaros Cetinel, and Nedim Cetinkaya. 2021. "The Effect of Trichoderma citrinoviride Treatment under Salinity Combined to Rhizoctonia solani Infection in Strawberry (Fragaria x ananassa Duch.)" Agronomy 11, no. 8: 1589. https://doi.org/10.3390/agronomy11081589
APA StyleSekmen Cetinel, A. H., Gokce, A., Erdik, E., Cetinel, B., & Cetinkaya, N. (2021). The Effect of Trichoderma citrinoviride Treatment under Salinity Combined to Rhizoctonia solani Infection in Strawberry (Fragaria x ananassa Duch.). Agronomy, 11(8), 1589. https://doi.org/10.3390/agronomy11081589

